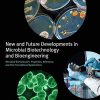
New and Future Developments in Microbial Biotechnology and Bioengineering: Microbial Biomolecules: Properties, Relevance, and Their Translational Applications (PDF)

Nanoparticles in Analytical and Medical Devices (PDF)
6 $
Delivery time: Maximum to 1 hours
Category: Clinical Medicine
Nanoparticles in Analytical and Medical Devices (PDF Book)
bySubash C.B. Gopinath(Editor), Fang Gang(Editor)
Nanoparticles in Analytical and Medical Devices presents the latest information on the use of nanoparticles for a diverse range of analytical and medical applications. Covers basic principles, proper use of nanoparticles in analytical and medical applications, and recent progress in the field. This comprehensive reference helps readers grasp the full potential of nanoparticles in their analytical research or medical practice. Chapters on cutting-edge topics bring readers up to date on the latest research and usage of nanoparticles, and a chapter on commercially available devices that utilize nanoparticles guides readers in overcoming issues with marketing biodevices.
Product Details
- Digital eBook:344 pages
- ISBN-10:0128211636
- ISBN-13:978-0128211632
- Item Weight:1.23 pounds
- Product Dimensions:6 x 0.72 x 9 inches
- Publisher:Elsevier; 1st Edition (September 16, 2020)
- Language::English